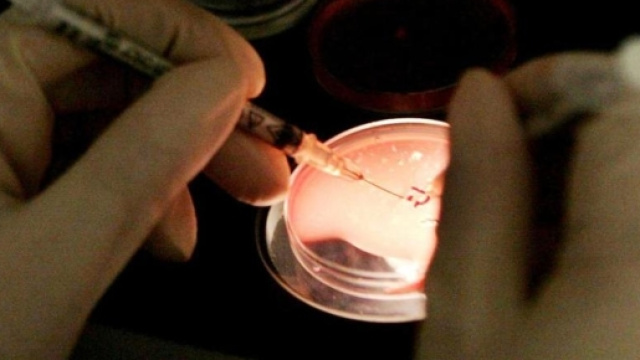
Allarme legionella a Parma: Pizzarotti criticato

Allarme legionella a Parma, dove la Procura ha aperto un'inchiesta, al momento contro ignoti, per omicidio colposo, lesioni colpose ed epidemia colposa. Si è reso necessario aprire un fascicolo d'inchiesta per l'aumento dei casi di legionella nel quartiere Montebello. La patologia ha colpito oltre 30 persone e ucciso due donne anziane.
Due persone sono in gravi condizioni per la legionella
Lo scopo dei sostituti procuratoriAndrea Amara e Giuseppe Bianchi è quello di individuare le cause dei contagi, in modo da delineare anche possibili responsabilità penali.
La legionella sta mettendo in ginocchio Parma e il sindaco Pizzarotti viene attaccato per la sua superficialità nel gestire la situazione. La Procura ha avviato l'inchiesta dopo la diffusione di notizie importanti da parte di numerosi organi di stampa e le informazioni ricevute dalle autorità sanitarie, che hanno subito iniziato a compiere gli accertamenti per scoprire il focolaio della legionella a Parma. Sembra che verranno esaminate anche le cartelle cliniche delle persone morte successivamente al contagio. Bisogna precisare che le anziane erano già malate prima del contagio. L'ultimo decesso è avvenuto martedì scorso, 4 ottobre 2016, presso l'ospedale Maggiore: si tratta di una 77enne. Nel nosocomio sono state ricoverate altre persone con i tipici sintomi della legionella: 2sono in gravi condizioni.
Attualmente, i casi di legionella a Parma sono 31. La Procura, sulla base degli accertamenti già svolti dalla Regione e dall'Ausl potrà ordinare autonomamente altre consulenze e perizie per fare luce sulla vicenda e scoprire eventuali responsabili. Intanto 16 persone si trovano al Maggiore per polmonite da legionella. Successivamente alla diffusione della notizia inquietante suiricoveri e idecessi a Parma, il sindaco Pizzarotti è stato attaccato duramente da diversi esponenti della minoranza.
Roberto Ghiretti biasima Pizzarotti
Roberto Ghiretti, consigliere comunale di Parma Unita, afferma che il sindaco Pizzarotti non ha ancora capito che deve agire tempestivamente, visto che i casi di legionella sono aumentati e, inoltre, si sono registrati 2 decessi.
Ghiretti, comunque, aveva già sferzato il primo cittadino di Prima tempo fa, sottolineando che Pizzarotti avrebbe dovuto informare i parmigiani sulle iniziative intraprese dal Comune, dalle autorità sanitarie e dalla Regione per contrastare la legionella, nonché sui comportamenti da assumere per ridurre i rischi. Il consigliere comunale sostiene che un vero sindaco deve schierarsi in prima linea e difendere i cittadini: secondo lui Pizzarotti se ne infischia dei parmigiani e prende le decisioni tardivamente. Un comportamento del genere è altamente rischioso, soprattutto quando c'è in gioco la vita di moltissime persone.
Giuseppe Pellacini: 'Il vero problema è Pizzarotti'
Stilettata a Pizzarotti anche da parte di Giuseppe Pellacini, consigliere comunale dell'Udc, secondo cui a Parma c'è un vistoso incremento dei casi di legionella ma, comunque, la vera problematica è il sindaco Pizzarotti e la sua leggerezza nella gestione dei problemi seri.
Pellacini ha fatto notare che i sindaci dei Comuni dove, negli ultimi mesi, si sono riscontrati casi di legionella hanno agito diversamente da Pizzarotti e, soprattutto, tempestivamente. Il sindaco di Massa Carrara, ad esempio, dopo aver appreso la notizia del caso di legionella in una scuola media, ha subito vietato il contatto con l'acqua. Secondo Pellacini, Pizzarotti si disinteressa della salute pubblica perché ha altre cose a cui pensare: lo comprova il fatto che sono state le autorità sanitarie a diffondere la notizia dell'aumento dei casi di legionella a Parma, non il primo cittadino.